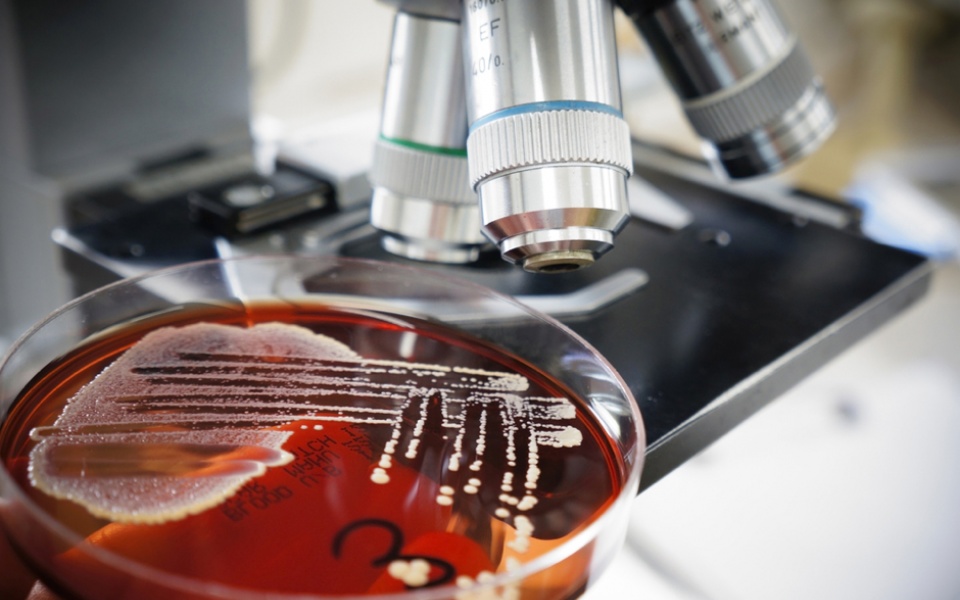

TIPS
TIPS

Microscopic organisms. Some they have beneficial properties; others can cause food-borne illnesses when foods contaminated with them are ingested.
Microscopic organisms. Some they have beneficial properties; others can cause food-borne illnesses when foods contaminated with them are ingested.

